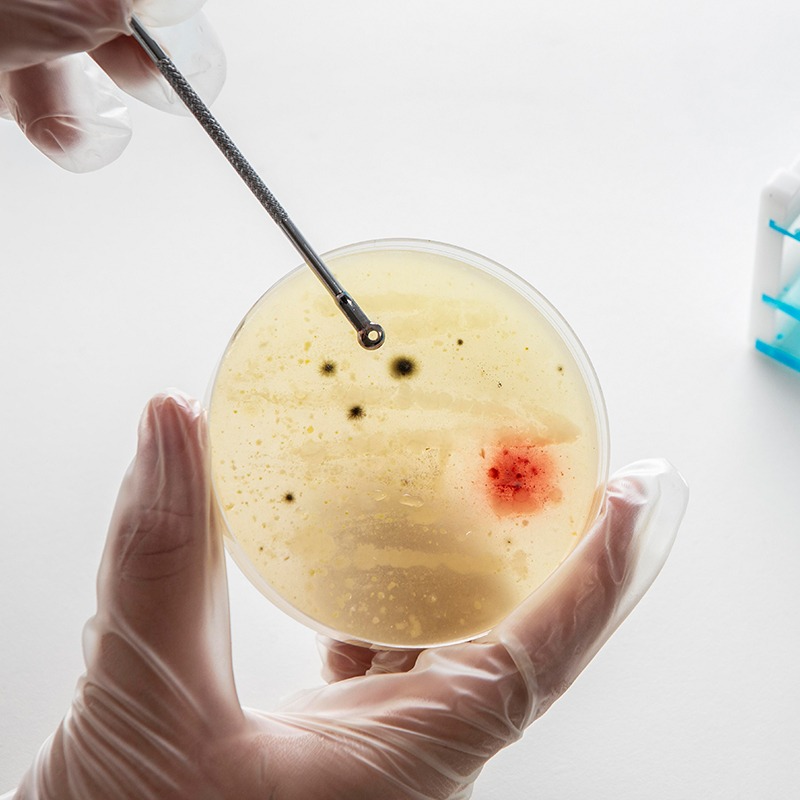

For many couples navigating the complexities of infertility, while In Vitro Fertilization (IVF) has revolutionized reproductive medicine, a specialized technique called Intracytoplasmic Sperm Injection (ICSI) has emerged as a crucial solution, particularly for couples facing male factor infertility or previous fertilization challenges. At Yashoda Fertility and IVF Centre, we are at the forefront of providing advanced fertility treatments, offering ICSI as a highly effective pathway to conception.
As a leading ICSI treatment Clinic and a distinguished Best ICSI clinic near me, Yashoda IVF Centre is committed to combining the latest advanced technology with compassionate care. Our experienced team of fertility specialists and embryologists are dedicated to maximizing your chances of success, ensuring a supportive and ethical journey towards building your family.
What is Intracytoplasmic Sperm Injection (ICSI)?
ICSI vs. IVF: When is ICSI Recommended?
The ICSI Process Step by Step at Yashoda IVF Centre
ICSI Treatment Cost and Sperm Injection Procedure Cost at Yashoda IVF Centre
The ICSI treatment cost is a significant consideration for many couples. As an advanced fertility treatment, ICSI procedure generally incurs a higher IVF with ICSI cost compared to conventional IVF due to the specialized equipment and highly skilled embryological techniques involved in the sperm injection procedure. At Yashoda Fertility and IVF Centre, we believe in transparent pricing and strive to make quality fertility care accessible.
This comprehensive cost typically includes:
Our financial counsellors at Yashoda IVF Centre are available to provide a detailed breakdown of all expenses, discuss payment plans, and clarify any questions regarding the ICSI treatment cost.
Why Choose Yashoda IVF Centre for Your ICSI Treatment?
When searching for the Best ICSI clinics near me, Yashoda Fertility and IVF Centre stands out for its unwavering commitment to excellence and patient success. Our clinic is renowned for:
If you are exploring advanced fertility treatments such as Intracytoplasmic Sperm Injection for your path to parenthood, we invite you to connect with Yashoda IVF Centre.
ICSI Questions
What is ICSI?
Who needs ICSI?
Is ICSI different from IVF?
Is ICSI safe for the baby?
How successful is ICSI?

Why Choose Us?




Contact us today!
Contact Us
Call Us 24/7: 8655442182
Working Time